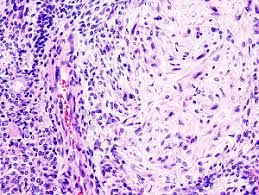
Unknown

Pleomorphic adenoma is a benign salivary gland tumor that exhibits wide cytomorphologic and architectural diversity.
The tumor has the following three components:
-
An epithelial cell component
-
A myoepithelial cell component
-
A stromal (mesenchymal) component
Identification of these three components, which may vary quantitatively from one tumor to another, is essential to the recognition of pleomorphic adenoma.
This tumor is also referred to as a benign mixed tumor.
Epidemiology
Pleomorphic adenoma is the most common salivary gland tumor in both children and adults.
In most series in the literature, it represents approximately 45% to 75% of all salivary gland neoplasms.

The annual incidence is approximately 2.0 to 3.5 cases per 100,000 population.
Pleomorphic adenoma occurs in individuals of all ages. However, it is most common in the third to sixth decades of life.
The average age at presentation is between 43 and 46 years.
Pleomorphic adenoma is seen more often in females than in males (2:1 ratio).
Etiology
Although the etiology of pleomorphic adenoma is unknown, the incidence of this tumor has been found to increase 15 to 20 years after exposure to radiation.
One study suggests that the simian virus (SV40) may play a causative role in the development of pleomorphic adenoma.
Location
Among the major salivary glands (parotid gland, submandibular gland, and sublingual gland), the tail of the superficial lobe of the parotid salivary gland is the most common site of occurrence for pleomorphic adenoma (70% to 80% of cases), although this lesion can occur in any parotid location.
The tumor is less commonly seen in the submandibular salivary gland (10%) and is seldom encountered in the sublingual gland (1%).
With regard to the minor salivary glands (5% to 10% of cases):
- The palate (specifically, the junction of the soft and hard palates) and the lip are the most common sites for pleomorphic adenoma.
- Other sites of minor salivary gland involvement include the nose, the paranasal sinuses, and the larynx.
Rare or unusual sites of occurrence include ectopic salivary gland tissues (eg, in the mandible, neck lymph nodes, or axilla). A case has been reported of a pleomorphic adenoma presenting as a midline nodule in the isthmus of the thyroid in a 66-year-old man.
Multiple tumors are unusual (1:40,000), but metachronous and synchronous tumors do occur.
Synchronous occurrence of pleomorphic adenoma and Warthin tumor (the second most common benign salivary gland tumor) has been reported
Clinical Features
Pleomorphic adenoma usually presents as a slow-growing, painless mass, which may be present for many years. Symptoms and signs depend on the location.

When the tumor occurs in the parotid gland, signs of facial nerve weakness are seldom encountered; however, if the tumor is large and has been neglected, facial nerve weakness is likely to arise as the result of malignant change.
Pleomorphic adenoma in the deep lobe of the parotid gland may present as an oral retrotonsillar mass or parapharyngeal space tumor; indeed, tumors arising at this site are the source of the most common parapharyngeal space tumors.
Rapid enlargement of a tumor nodule should raise concern about the development of malignant change.
Patients with minor salivary gland tumors may present with a variety of symptoms, depending on the site of the tumor; such symptoms include dysphagia, dyspnea, hoarseness, difficulty in chewing, and epistaxis.
Macroscopic Characteristics
On gross examination, a pleomorphic adenoma is a single firm, mobile, well-circumscribed mass.
Its color may vary from whitish-tan to gray to bluish, and its size may range from a few millimeters to quite large or even giant.
Pleomorphic adenomas are irregularly shaped and have a bosselated surface.
Degenerative and cystic changes may be seen on sectioning.
It is not unusual to observe evidence of focal or massive infarction.
Recurrent tumors characteristically tend to present as multiple nodules of variable size.
Rodrigo Arrangoiz MS, MD, FACS
Michigan State University
Cirugía Oncológica
Drexel University
Certificado por el Colegio Americano de Cirugía
Hospital ABC Santa Fé
Av. Carlos Graef Fernández #154
Col. Tlaxala, Delg. Cuajimalpa
México, D.F. 05300
Tel: 1103 – 1600 Ext 4515 a la 4517
Fax:1664 – 7164


